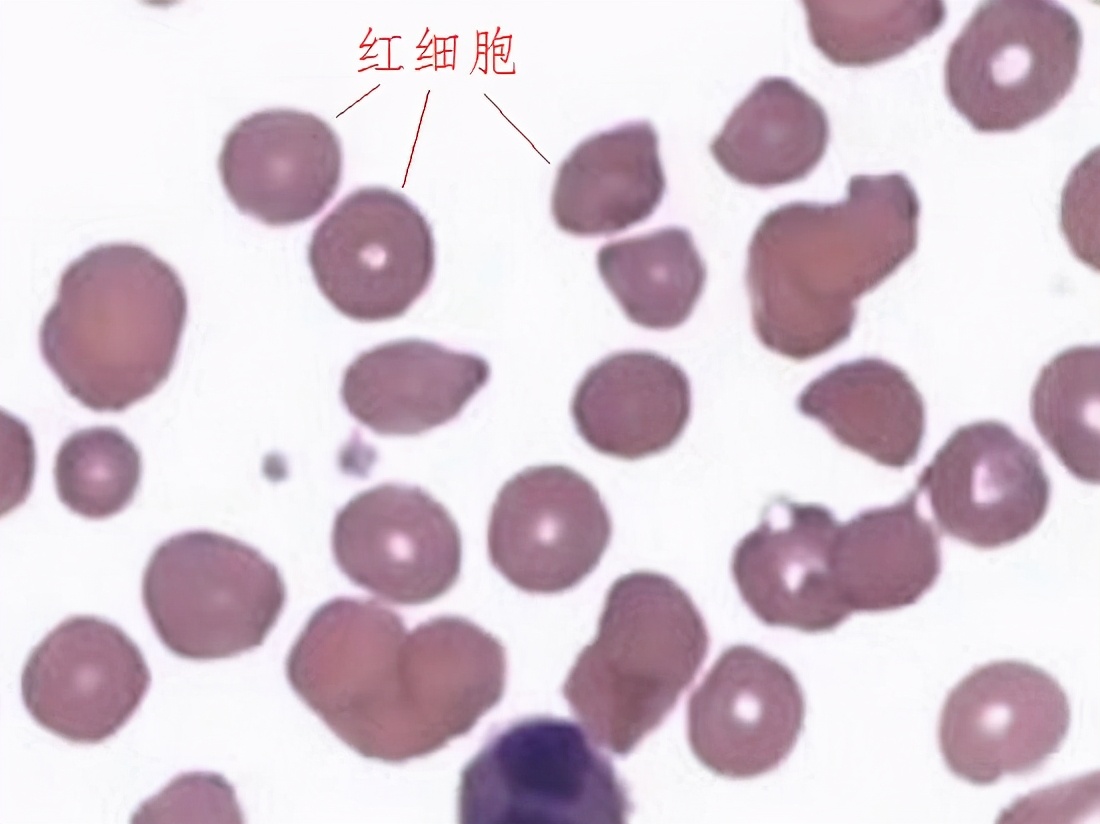
经期剧烈运动后尿血,运动后尿血是什么原因

在剧烈运动之后,有的人可能在小便时惊愕地发现自己的小便颜色发红,出现“尿血”现象。所谓尿血,是指尿液中出现不该出现的红细胞并形成血尿。红细胞广泛分布于血液之中,占据血液约一半的体积。尿液由肾过滤血液形成,正常情况下,肾小球可将体积巨大的红细胞隔绝于滤膜以外,不会有漏网之鱼,之所以出现尿血现象,一定是哪里出了问题。
肾损伤或膀胱损伤 对抗性运动(例如跆拳道)和剧烈运动可能会伤及肾脏和膀胱,使肾或膀胱内部的小血管破裂,使血液混入尿中形成血尿。

肾缺血、缺氧引发血尿 在高强度运动中,在神经系统的调节下,大脑、肠胃、肾等器官的血液会流往肌肉系统,这种现象可能会使肾脏因缺血、缺氧而出现暂时性的功能异常,使肾小球的过滤膜间隙变大并在滤血过程中将红细胞遗漏,进而形成血尿。

肾静脉高压 在长时间的站姿运动过程中(例如:马拉松长跑),肾脏可能会出现下垂,肾脏的位置变化可能会使肾静脉与下腔静脉出现交叉、互扭,这种现象会使肾静脉血管内的血液回流受阻,并在前端形成极高的静脉压,肾静脉压会使肾小球中本就偏高的血压再度升高,迫使滤膜裂隙张开,血液中的红细胞自然会乘机漏入原尿之中。

其他肾脏或尿道疾病 除了上述与运动直接相关的原因以外,还可能是因为运动者本身就患有肾结石、肾炎、肾外伤、肾下垂、肾畸形、尿路感染等疾病,这些疾病在日常生活中尚无异常表现,但却会在高强度的运动过程中被放大。因这类疾病引发的血尿问题需要前往正规医院寻求医生的帮助。

应对方法 1、防止运动外伤。在对抗性运动中应采用必要的防护手段,防止身体遭受打击。2、合理运动,降低运动强度。在训练和健身过程中应循序渐进、量力而行,不要试图通过体力透支的方式实施运动,那样既不会获得良好的运动效果,还会让健康受损。3、在高强度运动过程中适量补充水和电解质,适当休息。在身体脱水过程中补充水和电解质可以有效增加血容量,改善供血、供氧效率,防止内脏缺氧。4、为身体减震。身体从高处频繁落地的动作(例如:跨栏跑)会形成巨大的震动并引发肾下垂或膀胱受伤,可通过运动鞋或富有弹性的鞋垫实施减震、加以规避。